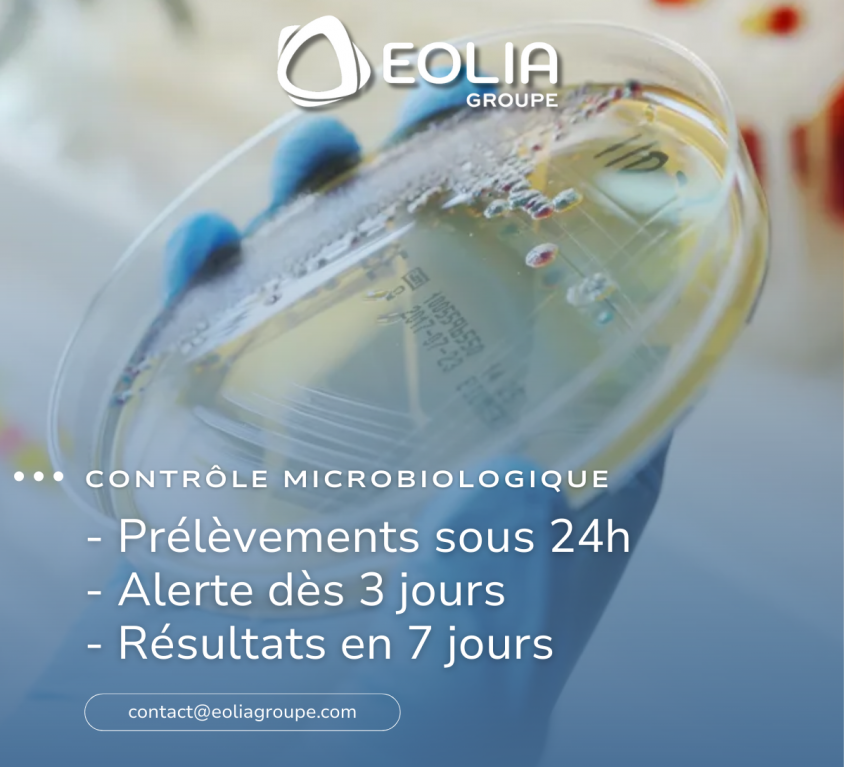
Contrôle microbiologique gagnez en réactivité, sécurisez vos environnements

Nous proposons la réhabilitation et la rénovation des systèmes de traitement de l’air.



Depuis 16 ans, EOLIA GROUPE répond aux enjeux sanitaires en accompagnant ses clients et partenaires sur une large gamme de services : Validation, Réalisation & Réhabilitation, Maintenance et Hygiénisation axée sur la maîtrise des risques.
Aujourd’hui, le groupe est réparti sur 3 régions : PACA, Île-de-France et Rhône-Alpes, ce qui lui confère une proximité essentielle pour répondre à la réactivité et à la traçabilité des projets.
À PROPOS DU GROUPE












NOS SECTEURS D'ACTIVITÉS



SECTEUR
HOSPITALIER
Nous intervenons dans le secteur hospitalier, des CHU aux CH en passant par les CHRU ou même les cliniques. Nous avons notamment travaillé avec plusieurs hôpitaux : APHM, APHP, CH Aubagne, CH Gap, CH Montpellier…



SECTEUR
PHARMACEUTIQUE
L’industrie pharmaceutique est soumise à une réglementation exigeante. L’équipe EOLIA effectue des interventions sur-mesure auprès d’entreprises du secteur comme AGEPS PARIS, l’ANSM, Becton Dickinson…



SECTEUR
AGROALIMENTAIRE
La qualité de l’air dans l’industrie agroalimentaire est strictement réglementée : la ventilation doit être suffisante et facilement accessible, il faut éviter les flux d’air pollués vers l’air sain…



SECTEUR
MICRO ÉLECTRONIQUE
Chez EOLIA, nous sommes des experts dans le secteur de la micro électronique. Des entreprises comme VIishay ou MXM ont fait confiance à notre savoir-faire dans le domaine de la qualité de l’air.
NOS AGENCES
agence en PACA
(siège social)
179 voie Atlas – ZI Athélia III
13600 La Ciotat
04 42 70 87 44
agence en Île-de-France
9-11 chemin de Chilly
Bâtiment B
91160 Champlan
01 81 87 10 29
agence en
Rhône-Alpes
13 allée des Tulipiers
69500 Bron
04 72 72 02 20
agence en PACA
301 AVENUE PIERRE ET MARIE CURIE
06700 SAINT-LAURENT-DU-VAR
04 72 72 02 20
LES ACTUALITÉS DE EOLIA GROUPE
Chez Eolia Groupe, nous sommes convaincus que la prise en charge des patients atteints de cancer ne se limite pas…
Parce que l’air pur commence… dans les endroits que l’on oublie ! Le constat : Vos équipements de traitement d’air…
Pourquoi le rétrofit ? Réhabiliter l’existant à neuf, augmenter les performances, sans perturbation de l’activité, tout en réduisant les coûts…
Chez Eolia groupe, nous avons fait le choix d’un laboratoire de microbiologie internalisé pour vous offrir plus de réactivité dans…
Jeudi 6 novembre, nous avons eu le plaisir de participer à la collecte des déchets organisée par La Ciotat entreprendre….
🔬 Notre laboratoire d’analyses microbiologiques à l’honneur ! Nous sommes fiers de voir notre laboratoire d’analyses microbiologiques mis en avant…